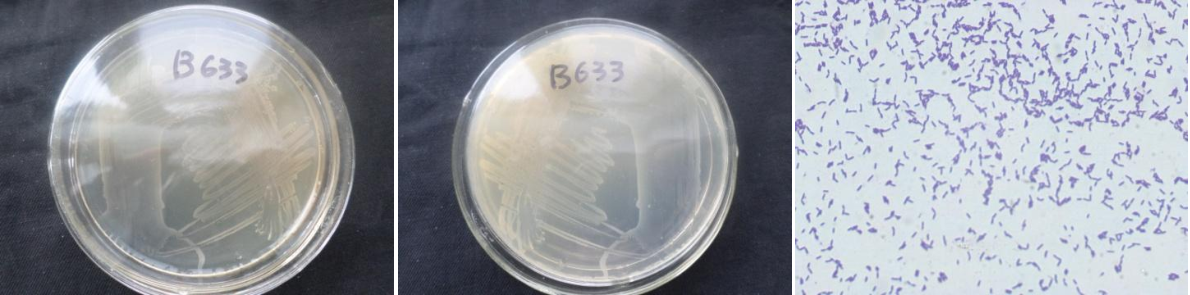

Loading...
| StrainNO | B633 |
| Classification | Terribacillus |
| 16s rDNA sequence | CCCTTAGGGCTCCTTGTTACGACTTCACCCCAATCATTGGTCCCACCTTCGGCGGCTGGCTCCAAAAGGTTACCTCACCGACTTC GGGTGTTACCAACTCTCGTGGTGTGACGGGCGGTGTGTACAAGGCCCGGGAACGTATTCACCGCGGCATGCTGATCCGCGATTAC TAGCGATTCCGGCTTCATGCAGGCGAGTTGCAGCCTGCAATCCGAACTGAGAATGGTTTTATGGGATTTGCTTGACCTCGCGGTT TTGCTTCCCTTTGTTCCATCCATTGTAGCACGTGTGTAGCCCAGGTCATAAGGGGCATGATGATTTGACGTCATCCCCACCTTCC TCCGGTTTGTCACCGGCAGTCACCTTAGAGTGCCCAACTTAATGCTGGCAACTAAGATCAAGGGTTGCGCTCGTTGCGGGACTTA ACCCAACATCTCACGACACGAGCTGACGACAACCATGCACCACCTGTCACTCTGTCCCCGAAGGGAACTTCCTATCTCTAGGAAT AGCAGAGGATGTCAAGACCTGGTAAGGTTCTTCGCGTTGCTTCGAATTAAACCACATGCTCCACCGCTTGTGCGGGCCCCCGTCA ATTCTTTTGAGTTTCAGCCTTGCGGCCGTACTCCCCAGGCGGAGTGCTTAATGCGTTAACTTCAGCACTAAAGGGGCGGAAACCC CCTAACACCTAGCACTCATCGTTTACGGCGTGACTACCAGGTATCTAATCCTGTTCGCTCCCCACGCTTTCGCTCCTCAGCGTCA GTTACAGACCAGAGAGTCGCCTTCGCCACTGGTGTTCCTCCACATCTCTACGCATTTCACCGCTACACGTGGATTCCACTCTCCT CTCTGTACTCAAGTCCTCCAGTTTCCAATGACCGTTCGCGGTTGAGCCGCGAGATTCACATCAGACTAAGGACCGCCTGCGAGCG CTTACGCCCAATATCGACACGCTGCCCTACGTATACGCGCTGCTGCACGTAGTAGCGGCTTCTGTAGTACGTCAGCGTCAGTACT ACCGACTGTCTCCTACAACAGAGTTTACGATCGAAACCTCATCACTCACGCGGCGGTGCTCCGTCGACTTTCGTCCAATGCGGAA GATCTACTGTCGTGCTCCGTAGGACTGGGCGGGGTCTCAGTCCAAGTGCAATCCCGATCAAGGTGGGTAGCAGCACTTGCACCTT TGTTGGAGCAAC |
| Strain Morphology Photos | |
| Morphological Description | Colony round;clam white;edge neatly;steamed bun shaped;slippy;sticky;Waxed;Rod;having spore;Bacteriophage telogen |